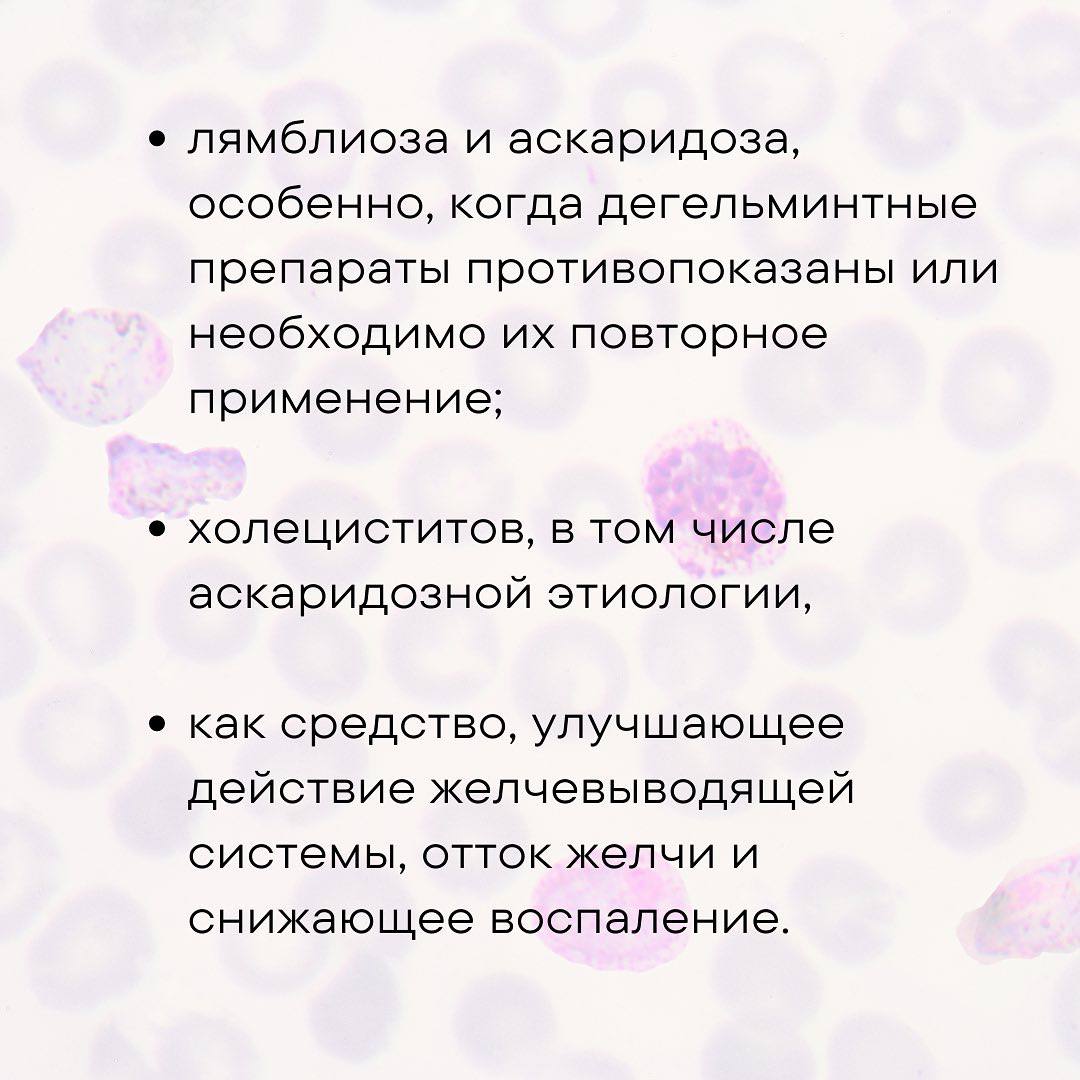
photo_1760945086513.jpg

Что значит почистить организм?
Важнейшая составляющая Концепции Здоровья — это этап очищения организма или программа детокс. Этот процесс направлен на выведение из тела токсинов, шлаков, продуктов жизнедеятельности патогенных микроорганизмов и других вредных веществ, которые накапливаются в результате неправильного питания, стрессов, плохой экологии и других негативных факторов. Загрязненный организм не может функционировать на полную мощность, что приводит к различным недомоганиям и снижению общего самочувствия.
Вы удивитесь, но многие проблемы, связанные со здоровьем, связаны именно с тем, что в нашем кишечнике присутствуют паразиты. Эти непрошеные гости могут быть самых разных видов: от микроскопических простейших до более крупных гельминтов. Они питаются за счет нашего организма, выделяя при этом токсины, которые отравляют нас изнутри. Симптомы их присутствия могут быть разнообразны: от проблем с пищеварением (вздутие, боли, запоры или диарея) до аллергических реакций, угревой сыпи, хронической усталости, снижения иммунитета, а иногда даже более серьезных нарушений. Паразиты могут поражать не только кишечник, но и другие органы, включая печень, легкие, мозг и мышцы, что делает борьбу с ними крайне важной для поддержания здоровья.
Еломил (Yelomil) от компании Aurora мягко, но эффективно очистит ваш организм от паразитов. Этот натуральный комплекс разработан на основе тщательно подобранных растительных компонентов, известных своими антипаразитарными свойствами. В его состав входят экстракты таких растений, как гвоздика, черный орех, полынь, пижма и другие, которые обладают широким спектром действия против различных видов паразитов, не нанося при этом вреда полезной микрофлоре кишечника и слизистой оболочке. Важно отметить, что Еломил не только уничтожает взрослых особей, но и препятствует развитию личинок и яиц паразитов, обеспечивая комплексное очищение. Его мягкое действие делает его безопасным для регулярного использования и подходящим для людей с чувствительным пищеварением.
Подробнее в карусели. В нашей компании есть множество программ по очищению организма, и в каждой из них есть этот незаменимый продукт. Мы понимаем, что очищение организма – это комплексный процесс, поэтому предлагаем различные программы, учитывающие индивидуальные потребности каждого человека. Эти программы могут включать не только антипаразитарную терапию, но и очищение печени, почек, лимфатической системы, а также восстановление микрофлоры кишечника. Еломил является ключевым компонентом многих из этих программ, обеспечивая мощную поддержку в борьбе с паразитарными инвазиями.
Мы будем продолжать тему очищения организма. Оставайтесь с нами. В наших следующих публикациях мы подробно расскажем о том, как правильно подготовиться к программе очищения, какие существуют виды детокса, как распознать признаки зашлакованности организма и какие продукты способствуют его естественному очищению. Мы также поделимся историями успеха наших клиентов и ответим на самые частые вопросы, связанные с оздоровлением и профилактикой заболеваний.
А вы проводите антипаразитарную программу? Поделитесь своим опытом в комментариях! Ваше мнение и вопросы очень важны для нас.
📱 https://t.me/auroraproduct: https://kompaniya-aurora.online/
